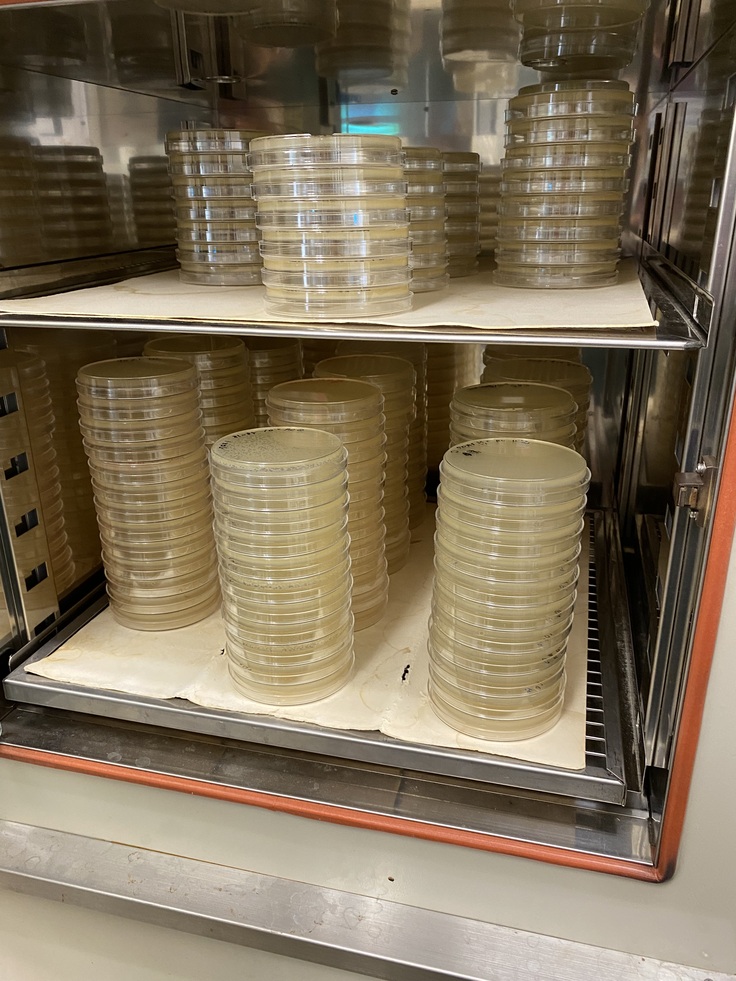

寄付総額
目標金額 7,000,000円
- 寄付者
- 311人
- 募集終了日
- 2022年8月29日
まずは、成立!。そして、次のステージへ!!
みなさま
初期目標の700万円突破をスタートから1ヶ月を前に到達するとは・・、夢にも思いませんでした。ご理解、ご支援をいただきまして、本当に感謝いたします。
この1ヶ月、突っ走って来ました。まずは自分の身近な繋がりを辿りながら、少しずつ輪が広がっていく、それは当初クラウドファンディングを始める時に説明を受けた通りでした。今は、私が把握する外側の人々にその支援の輪が着実に広がっているのを実感しております。それと同時に、単なる資金援助ではなく、みなさんの期待とそれに応えるべく実用化に向けたさらなる意識が高まって来ています!このクラウドファンデイングは、確実に我々の研究のステージを上げてくれるものとなっております。
ここからは、さらに多くの人々にこの治療法の開発について知っていただきたいと思っています。そこで学生向け3000円コースという部分の「学生向け」を取り払って、多くの人が支援をしやすいように変更しました。目標は500人以上を目指して行きたいと思います!あと1ヶ月ですが、さらなる目標へ向けて発信して行きたいと思います。
さて、まだお知らせしていなかったことがあります。
現在、臨床試験、国内3例目となる犬の外耳炎に対するファージセラピーが始まっています。連日、朝早くから遅くまで治療とその効果判定に追われています!!よって、こんな遅くに発信となってしまいました、すみません(苦笑)。学生もかなり頑張ってくれています。ワンちゃんの症状は快方に向かっていますが、ここからが勝負です。また、詳細は今度まとめてご報告したいと思います!
みなさん、成功を祈っててください!今後ともどうぞよろしくお願いいたします!
以下、その日常の写真を少し送りますね。


毎日、何十枚もの培地(細菌を培養する栄養リッチな寒天)で細菌を培養し、ファージをハンティング(様々な環境汚水から分離すること)して来ました。その時の写真です、この箱の中で37度を保って一晩培養します!!
ファージが細菌を死滅させるかどうかの簡易判定の写真です。
きれいに丸く透明に見えている部分は、ファージが細菌に感染し破壊したところとなります。

ギフト
3,000円+システム利用料

3千円|応援コース
・お礼のメール
・活動報告レポート
・寄付領収証明書 ※寄付領収証明書の宛名はギフトのお届け先として登録されているお名前となります
・酪農学園基金HPにご芳名を掲載 ※希望者のみ
・オリジナルキャラクターのスマホ壁紙
※寄付領収証明書は、本学園への入金日の2022年10月の日付になり、2022年10月中旬から11月ごろの発送を予定しております。
- 申込数
- 99
- 在庫数
- 制限なし
- 発送完了予定月
- 2023年3月
10,000円+システム利用料

1万円|クリアファイルコース
・お礼のメール
・活動報告レポート
・寄付領収証明書 ※寄付領収証明書の宛名はギフトのお届け先として登録されているお名前となります
・酪農学園基金HPにご芳名を掲載 ※希望者のみ/ギフトのお届け先として登録されているお名前が掲載されます
・オリジナルキャラクターのスマホ壁紙
・オリジナルキャラクターのクリアファイル
※寄付領収証明書は、本学園への入金日の2022年10月の日付になり、2022年10月中旬から11月ごろの発送を予定しております。
- 申込数
- 151
- 在庫数
- 制限なし
- 発送完了予定月
- 2023年3月
3,000円+システム利用料

3千円|応援コース
・お礼のメール
・活動報告レポート
・寄付領収証明書 ※寄付領収証明書の宛名はギフトのお届け先として登録されているお名前となります
・酪農学園基金HPにご芳名を掲載 ※希望者のみ
・オリジナルキャラクターのスマホ壁紙
※寄付領収証明書は、本学園への入金日の2022年10月の日付になり、2022年10月中旬から11月ごろの発送を予定しております。
- 申込数
- 99
- 在庫数
- 制限なし
- 発送完了予定月
- 2023年3月
10,000円+システム利用料

1万円|クリアファイルコース
・お礼のメール
・活動報告レポート
・寄付領収証明書 ※寄付領収証明書の宛名はギフトのお届け先として登録されているお名前となります
・酪農学園基金HPにご芳名を掲載 ※希望者のみ/ギフトのお届け先として登録されているお名前が掲載されます
・オリジナルキャラクターのスマホ壁紙
・オリジナルキャラクターのクリアファイル
※寄付領収証明書は、本学園への入金日の2022年10月の日付になり、2022年10月中旬から11月ごろの発送を予定しております。
- 申込数
- 151
- 在庫数
- 制限なし
- 発送完了予定月
- 2023年3月

利尻 島猫サポーター募集!利尻島の不幸な野良猫を”ゼロ”に!!
- 総計
- 28人

何があっても、駆けつける。救急医療の生命線「病院救急車」の更新へ
- 現在
- 25,427,000円
- 寄付者
- 294人
- 残り
- 28日

飼い主のいない猫達に無料で避妊去勢が受けられるしくみサポーター募集
- 総計
- 59人

ハッピーりぼんサポーター募集!人と動物が共に生きる社会を目指して!
- 総計
- 25人

飼い主のいない犬と猫へ医療費を届ける|ハナプロサポーター
- 総計
- 664人

結んだ絆、ほどけないように。リーフノットサポーター募集中!
- 総計
- 107人

猫の変サポーター 野良猫ゼロプロジェクト
- 総計
- 39人

もっと多くの命を繋ぎたい!野生猛禽類の救護と継続飼育体制の充実を
- 支援総額
- 51,959,000円
- 支援者
- 3,400人
- 終了日
- 2/29

チンチラとの暮らしを守りたい。未解明な飼育方法を確かなものへ
- 支援総額
- 3,155,000円
- 支援者
- 211人
- 終了日
- 4/26

三重県熊野市にある五郷小学校の全校生徒に熊野杉の椅子を導入したい!
- 支援総額
- 1,267,000円
- 支援者
- 92人
- 終了日
- 8/24
お母さんの夢が私の夢に。安心して食べれるおやつを提供したい!
- 支援総額
- 10,000円
- 支援者
- 1人
- 終了日
- 7/29

世界遺産登録「花の窟神社」の水稲を復活させ、後世に残したい。
- 支援総額
- 546,000円
- 支援者
- 26人
- 終了日
- 8/18

【魅せます、空跳!】笑顔と感動、そしてよさこいの魅力を皆様に!
- 支援総額
- 851,000円
- 支援者
- 62人
- 終了日
- 7/31

大好きなスポーツを諦めない。車いすフェンサーへの転身で世界へ
- 支援総額
- 1,513,000円
- 支援者
- 58人
- 終了日
- 6/28












